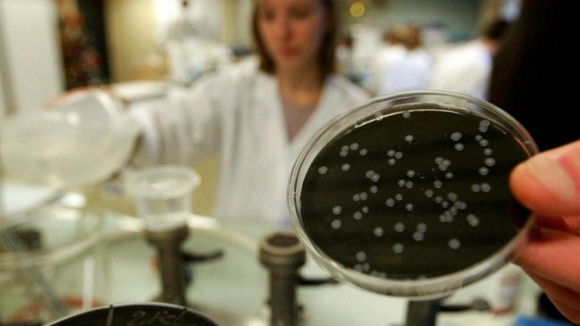
Bact&eacute;ria &acute;legionella&rsquo; detetada em balne&aacute;rios de pavilh&atilde;o de Oliveira do Bairro

Bactéria ´legionella’ detetada em balneários de pavilhão de Oliveira do Bairro
Porto Canal/ Agências
A presença da bactéria ‘legionella’ foi detetada em três de oito balneários do Pavilhão Desportivo Municipal de Oliveira do Bairro, no âmbito de análises de rotina para controlo da qualidade da água, confirmou esta quinta-feira a Câmara Municipal.
“De imediato, e em estreita articulação com a delegada de Saúde da Unidade Local de Saúde da Região de Aveiro, foram ativados todos os procedimentos técnicos e sanitários previstos para estas situações, os quais se encontram em curso”, destacou.
De acordo com esta autarquia do distrito de Aveiro, apesar da bactéria ter sido detetada, os balneários continuam a ser utilizados, com exceção da área destinada aos duches.
“A decisão relativa à utilização dos balneários foi tomada de forma conjunta entre a referida autoridade de saúde pública e o Município, tendo como prioridade absoluta a proteção da saúde dos utilizadores, permitindo a continuidade da utilização do Pavilhão Municipal, face à falta de alternativa para as aulas de Educação Física do Agrupamento de Escolas e do Instituto Profissional da Bairrada e para as atividades de treino e competição dos clubes desportivos que usufruem habitualmente deste equipamento”, referiu.
Neste momento, os utentes “estão a tomar banho noutras instalações do Parque Desportivo Municipal, localizadas nas proximidades do pavilhão”.
“Mais se informa que o Município continua a implementar as medidas corretivas necessárias, em conformidade com as orientações das autoridades de saúde, assegurando um acompanhamento rigoroso de todo o processo, de modo a garantir um ambiente seguro e saudável em todos os seus equipamentos”, afirmou.
O Município de Oliveira do Bairro sublinhou ainda que todas as normas legais aplicáveis neste âmbito têm sido “rigorosamente cumpridas”, tendo em vista o “bem-estar e segurança dos seus munícipes”.
A ‘legionela’ é uma bactéria que pode causar uma infeção pulmonar grave conhecida como Doença dos Legionários (tipo de pneumonia) e está presente no meio aquático: em sistemas de água domésticos, jacuzzis e piscinas, mas também na natureza, em rios e lagos.

